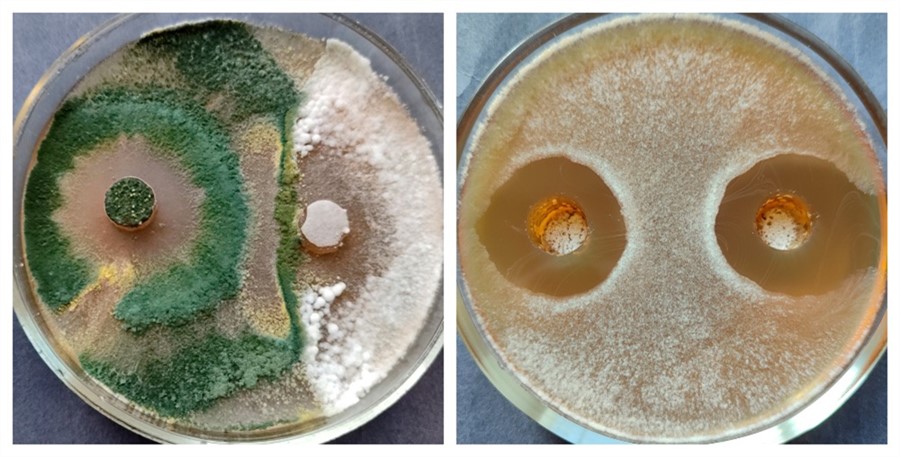
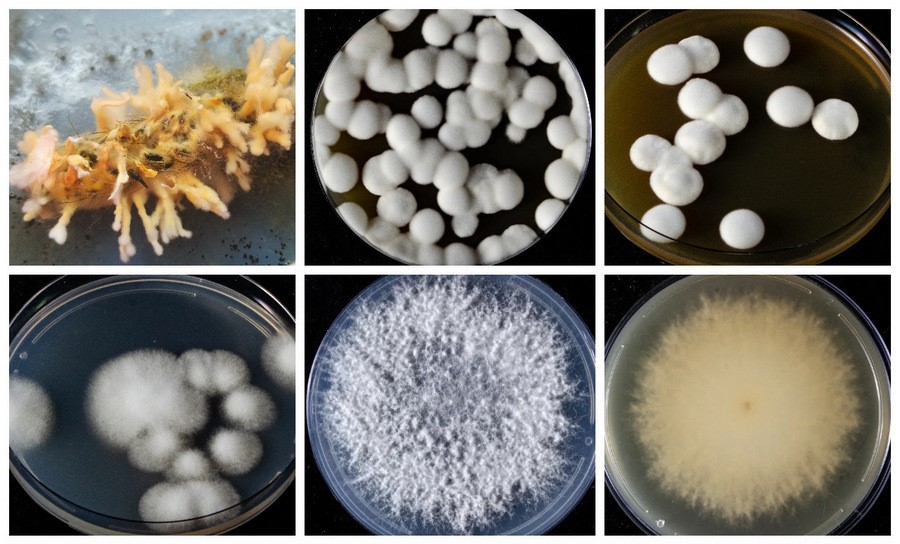

Новая модель сельского хозяйства
Основой для разработки красноярских ученых стала уникальная научная коллекция, которая хранится в Институте леса им. В.Н. Сукачева СО РАН. Банк насчитывает более полутора тысяч штаммов микроорганизмов, собранных из разных экосистем.
Большинство из них прошли молекулярно-генетическую идентификацию, а для части уже расшифрованы полные геномы. Это позволяет не просто классифицировать микроорганизмы, но и понимать механизмы их взаимодействия с патогенами, чтобы целенаправленно отбирать самые перспективные штаммы. Именно они — грибы-антагонисты, паразиты и убийцы насекомых — становятся основой для биопрепаратов нового поколения.

Отбор штамма и создание на его основе готового продукта — длительный процесс. Сначала ученые исследуют его защитные свойства, затем подбирают условия для выращивания, определяют оптимальные дозы и способы применения.
Ожидается, что внедрение таких методов позволит сократить затраты на химические обработки до 20 % без потери урожайности, а главное — снизить содержание пестицидов в конечной продукции и защитить насекомых-опылителей, особенно медоносных пчел.
Как работает биозащита
Принцип биологической защиты основан на естественных механизмах. В природе у каждого организма, включая грибы-вредители, есть естественные враги. Ученые выделили высокоактивные штаммы микроскопических грибов и бактерий, которые способны подавлять возбудителей болезней леса и сельскохозяйственных растений.
Одно из самых перспективных средств — биопрепарат на основе гриба триходерма (Trichoderma asperellum) для защиты рапса от целого комплекса заболеваний, в том числе фузариоз и склеротиниоз. В отличие от химикатов, он абсолютно безопасен. Этот гриб особенно эффективен против агрессивного патогена Sclerotinia sclerotiorum, который образует в почве плотные структуры — склероции — и может сохраняться там до 20 лет, будучи неуязвимым для химии.
Штамм триходермы работает сразу в трех направлениях: во-первых, как антагонист, он ограничивает рост патогена; во-вторых, как микопаразит, разрушает его «спящие» формы в почве; в-третьих, как стимулятор роста, он помогает самому рапсу лучше развиваться. Эффективность препарата ученые отслеживают с помощью уникального метода, разработанного совместно с коллегами-физиками. Они анализируют флуоресценцию — характерное свечение хлорофилла в листьях. По спектру свечения можно точно сказать, здорово ли оно.
«Биофунгицид на основе Trichoderma asperellum уже проходит испытания на опытных посевах рапса в Красноярском крае и показал существенное снижение поражения растений, сохранение высокой фотосинтетической активности и увеличение ростовых показателей», — отмечает Игорь Павлов.
Грибы против насекомых
Еще одна проблема химических обработок — массовая гибель пчел. Важнейшее преимущество биопрепаратов — их избирательность. Они действуют только на конкретных вредителей.
Специалисты Института леса отобрали перспективные штаммы гриба боверия (Beauveria bassiana) для борьбы с рапсовым цветоедом. Эти же штаммы показали высокую эффективность и против лесных вредителей, таких как сибирский и непарный шелкопряд, уссурийский полиграф.
Споры этого гриба прилипают к покровам насекомого, прорастают внутрь, выделяют ферменты и токсины, убивая вредителя изнутри. При этом гриб способен долго жить на растительных остатках. Достаточно одной обработки прилегающих к полям перелесков, чтобы создать долговременный биологический барьер.
Также гриб естественным образом распространяется в популяции насекомых, благодаря их социальному поведению, контролирует популяцию и не дает уничтожать растения.

Вирусы в борьбе за здоровье растений
Новейшее направление — использование грибных вирусов (миковирусов). Ученые ищут вирусы, которые заражают и ослабляют вредоносные грибы, снижая их способность вызывать болезни у растений. Такой вирус, однажды попав в популяцию гриба-вредителя, распространяется в ней самостоятельно, осуществляя постоянный и долговременный контроль.
Современные технологии высокопроизводительного чтения геномов позволили ученым выявить в своей коллекции уникальные штаммы патогенных грибов, уже инфицированные вирусами. Например, найдены вирусы, которые лишают опасный гриб Sclerotinia возможности «прятаться» в почве, и другие, блокирующие его размножение.
«Особенность вирусных агентов — в их исключительной избирательности. Они целенаправленно поражают мишень, не затрагивая другие организмы», — подчеркивает Игорь Павлов.
По его словам, препараты на основе таких вирусов будут воздействовать не на растения или почву, а непосредственно на патогенный гриб, что минимизирует экологическую нагрузку.

В перспективе эти разработки могут предложить устойчивую альтернативу химическим пестицидам, повысить урожайность и привести к производству по-настоящему безопасных продуктов питания.
Следующий этап — масштабирование технологий и их внедрение на агропредприятиях. Интеграция таких исследований с промышленностью может стать основой для новой, экологически устойчивой модели сельского хозяйства.
Материал подготовлен при поддержке Минобрнауки России в рамках Десятилетия науки и технологий, фото предоставлено КНЦ СО РАН.